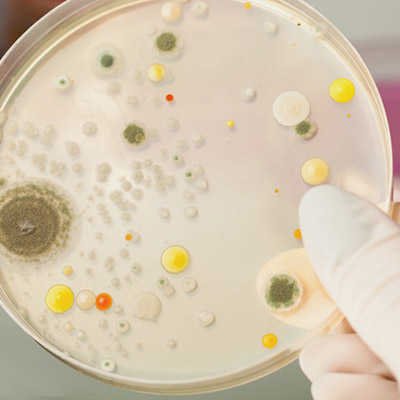
Erneuerung unserer Hygienezertifizierung

Sehr geehrte Geschäftspartnerinnen und Geschäftspartner,
wir möchten hiermit mitteilen, dass nach über 50 Jahren der aktive Betrieb der Michelbach GmbH zum 31.12.2023 beendet wurde.
Herr Holger Michelbach, Geschäftsführer der AFT GmbH & Co.KG und Sohn des Firmengründers, übernahm die Firma 2021 von
seinem Vater Ludwig Michelbach. Im Rahmen einer Zusammenführung werden diese beiden Firmen nun zu einem großen
Familienunternehmen und firmieren unter dem gemeinsamen Namen AFT GmbH & Co. KG weiter.
Die Ihnen bekannten Ansprechpartner wurden lückenlos übernommen und stehen Ihnen weiterhin zur Verfügung.
Verbunden hiermit möchten wir Sie auf unsere neue E-Mail-Struktur hinweisen.
Alle Nachrichten senden Sie in Zukunft bitte an: info@aft-gmbh.de oder direkt zu Ihrem Ansprechpartner: „nachname“@aft-gmbh.de
Mit freundlichen Grüßen
Ihr Team der AFT GmbH & Co. KG